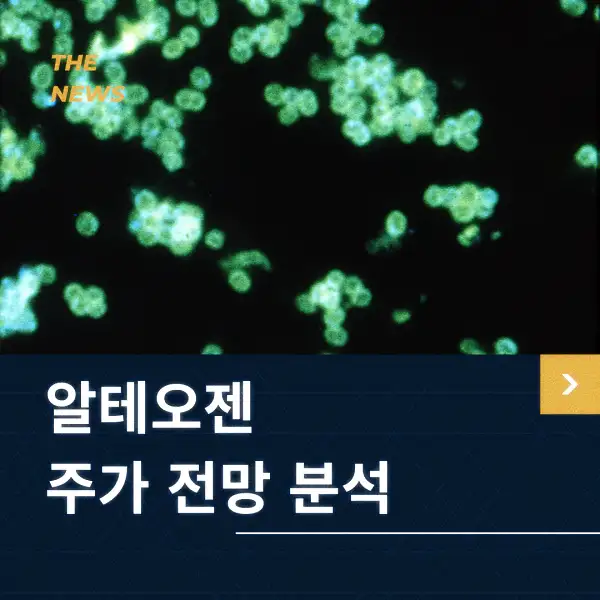
알테오젠 주가 전망 및 분석

알테오젠 주가 전망 및 분석 | 2025년 2월 2주차
알테오젠 주가 전망 2025년 분석! 2월 15일 기준 최신 정보 업데이트. 현재 주가 394,000원, 글로벌 라이선스 아웃 계약과 바이오시밀러 시장 성장으로 투자 매력 급부상! 상승 요인, 하락 리스크, 목표 주가 및 투자 전략까지 완벽 정리! 알테오젠 투자 전 필수 확인하세요!

1. 알테오젠 개요 및 기업 소개
알테오젠(ALTEOGEN, KOSDAQ:196170)은 국내 대표적인 바이오시밀러 및 항체-약물 결합체(ADC) 기술을 보유한 바이오 기업으로, 지속적인 연구 개발을 통해 글로벌 시장에서도 주목받고 있습니다. 특히, 피하주사 제형 변경 기술인 Hybrozyme 플랫폼 기술을 기반으로 한 라이선스 아웃(L/O) 계약이 활발히 진행되면서, 알테오젠 주가의 변동성이 커지고 있습니다.
2025년 2월 15일 현재, 알테오젠 주가는 394,000원에 장을 마감했으며, 최근 바이오 업종의 흐름과 함께 큰 주목을 받고 있습니다. 이번 글에서는 알테오젠 주가 전망을 심층 분석하여 투자자들에게 유익한 정보를 제공하겠습니다.

2. 2025년 2월 15일 기준 알테오젠 주가 현황
- 현재 주가: 394,000원
- 52주 최고가: 450,000원
- 52주 최저가: 220,000원
- 시가총액: 약 6조 원
- PER(주가수익비율): 75배
- PBR(주가순자산비율): 12배
최근 알테오젠 주가는 연이은 글로벌 기술이전(L/O) 성과 및 임상 시험 진행 상황에 따라 급등락을 보이고 있습니다. 특히, 글로벌 제약사와의 협력이 강화되고 있으며, 바이오시밀러 및 ADC 관련 기술의 경쟁력이 부각되면서 긍정적인 평가를 받고 있습니다.

3. 알테오젠 주가 상승 요인
3.1. 글로벌 라이선스 아웃 계약 확대
알테오젠은 자체 개발한 Hybrozyme 기술을 활용해 다수의 글로벌 제약사와 라이선스 아웃 계약을 체결하고 있으며, 추가적인 계약도 기대되고 있습니다. 2024년 하반기에 이어 2025년에도 추가적인 기술이전이 이뤄질 가능성이 높아 주가 상승의 핵심 요인이 될 것으로 예상됩니다.
3.2. 바이오시밀러 시장 성장
현재 글로벌 바이오시밀러 시장은 연평균 15% 이상의 성장세를 기록하고 있습니다. 알테오젠은 항체-약물 결합체(ADC) 및 바이오시밀러 기술을 기반으로 경쟁력을 강화하고 있으며, 향후 글로벌 시장 진출이 본격화될 경우 알테오젠 주가에 긍정적인 영향을 미칠 것으로 보입니다.
3.3. 기관 및 외국인 투자자 유입
최근 기관 및 외국인 투자자의 매수세가 지속적으로 증가하고 있습니다. 특히, 바이오 섹터에 대한 기관의 투자 비중이 확대되면서, 알테오젠 주가는 추가적인 상승 가능성을 내포하고 있습니다.

4. 알테오젠 주가 하락 요인
4.1. 바이오 업종의 변동성
바이오 관련 종목들은 임상시험 결과 및 규제 변화 등에 따라 변동성이 큽니다. 알테오젠 역시 임상 결과에 따른 주가 변동성이 존재하며, 예상과 다른 결과가 나올 경우 단기적으로 하락할 가능성이 있습니다.
4.2. 경쟁사와의 기술 격차
현재 글로벌 바이오 기업들도 ADC 및 바이오시밀러 기술을 개발 중이며, 경쟁이 치열한 시장입니다. 알테오젠이 지속적인 기술 개발 및 글로벌 제약사와의 협력 관계를 유지할 수 있을지가 중요한 변수가 될 것입니다.
4.3. 금리 인상 및 거시경제 환경
미국 연방준비제도(Fed)의 금리 정책 및 글로벌 경기 둔화 우려도 알테오젠 주가에 영향을 미칠 수 있는 요인입니다. 금리가 높아지면 성장주(바이오 기업 포함)에 대한 투자 매력이 감소할 수 있습니다.
5. 알테오젠 주가 전망 (2025년 2월~2025년 하반기)
5.1. 긍정적 시나리오 (목표 주가: 450,000원~500,000원)
- 추가적인 글로벌 라이선스 아웃 계약 성사
- 임상시험 성공 및 신약 승인 기대감 증가
- 바이오 업종 투자 확대 및 기관 매수 지속
5.2. 중립적 시나리오 (목표 주가: 370,000원~420,000원)
- 기존 계약 유지 및 일부 신규 계약 체결
- 바이오 업종 변동성 지속
- 글로벌 경제 불확실성 반영
5.3. 부정적 시나리오 (목표 주가: 300,000원~350,000원)
- 기술 이전 실패 및 임상시험 결과 부진
- 경쟁사 기술력 우위로 시장 점유율 감소
- 거시경제 악화 및 금리 상승 지속

📍 최근 정보
📌 가치 분석
6. 투자 전략
알테오젠은 바이오시밀러 및 ADC 기술을 기반으로 글로벌 시장에서 영향력을 확대하고 있는 기업으로, 장기적으로 긍정적인 전망을 가질 수 있습니다. 그러나 바이오 업종의 특성상 임상시험 및 기술이전 성과에 따라 변동성이 크므로 신중한 접근이 필요합니다.
투자 전략
- 장기 투자: 알테오젠의 핵심 기술과 글로벌 시장 확대 가능성을 고려할 때, 장기적인 투자 관점에서 접근하는 것이 유리할 수 있습니다.
- 단기 매매: 주가 변동성이 높은 만큼 단기적인 이슈(기술이전, 임상 결과 발표 등)를 활용한 매매 전략도 고려할 수 있습니다.
- 분할 매수 전략: 변동성이 큰 바이오 종목 특성상, 특정 가격대에서 분할 매수하는 것이 리스크를 줄이는 방법이 될 수 있습니다.

7. 마무리
2025년 2월 15일 기준 알테오젠 주가는 394,000원으로 마감되었으며, 향후 기술 이전 계약 및 임상시험 결과에 따라 큰 변동성이 예상됩니다. 알테오젠의 미래 성장 가능성을 고려할 때 장기적인 투자 매력이 있지만, 단기적으로는 신중한 접근이 필요합니다.











'증권정보 > 국내' 카테고리의 다른 글
| 필옵틱스 주가 전망 및 분석 | 2025년 2월 3주차 (0) | 2025.02.17 |
|---|---|
| 고영 주가 전망 및 분석 | 2025년 2월 2주차 (0) | 2025.02.16 |
| 제주반도체 주가 전망 및 분석 | 2025년 2월 2주차 (1) | 2025.02.14 |
| 전진건설로봇 주가 전망 및 분석 | 2025년 2월 2주차 (0) | 2025.02.13 |
| 올릭스 주가 전망! 일라이 릴리 기술이전으로 급등, 앞으로의 방향은? (0) | 2025.02.12 |
댓글